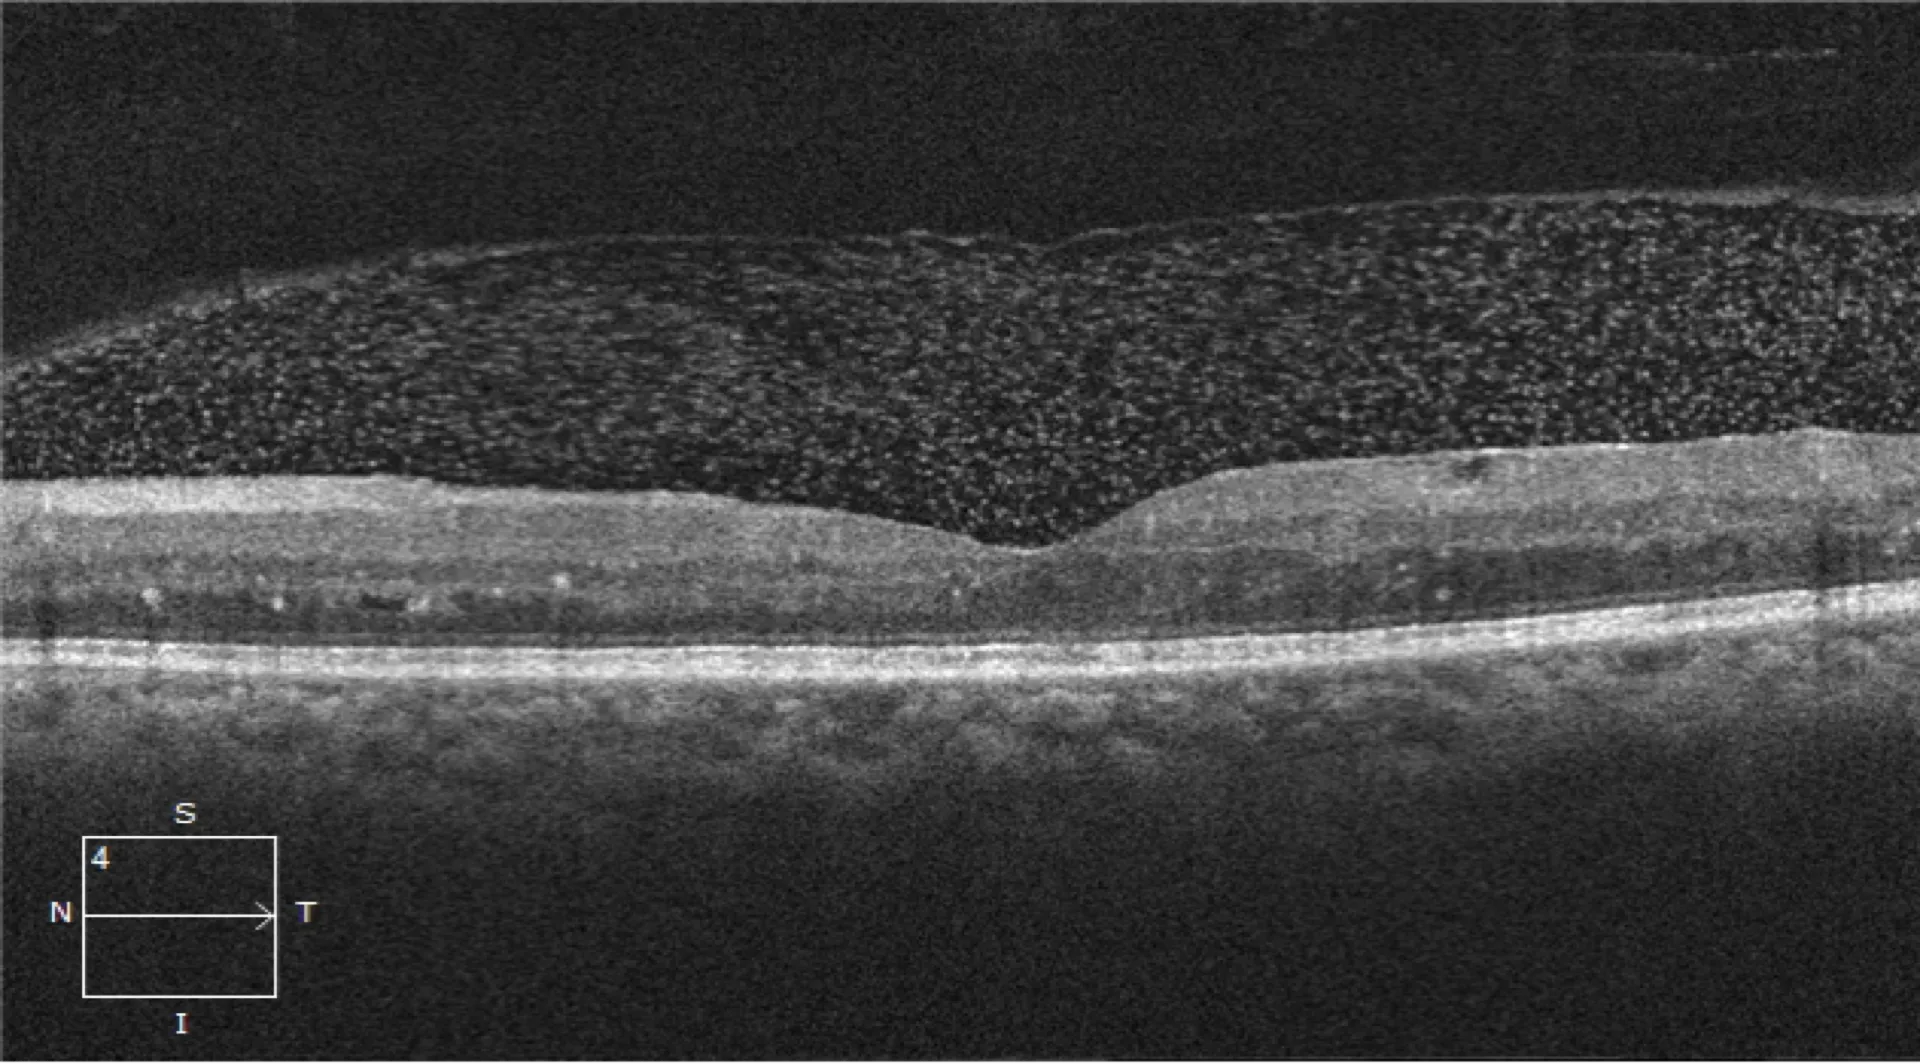

Training Programs
Advance an ophthalmology career with world‑class Training programs in Medical Retina, Glaucoma Management, and Refractive Surgery.
Our Training Programs
Choose from our comprehensive range of specialized Training programs designed to advance your expertise in various subspecialties of ophthalmology
Advanced training in vitreo-retinal disease with world-class faculty
Comprehensive course in glaucoma diagnosis and management
Advanced training in modern refractive surgery techniques
Detailed Program Information
Explore comprehensive details about each Training program including curriculum, faculty, and training methodology.
Medical Retina Training Program
This intensive hands-on program is designed to provide ophthalmologists with focused exposure to the fundamentals and practical aspects of Medical Retina. The course integrates imaging, lasers, and intravitreal procedures with case-based learning, enabling participants to build confidence in diagnosis and management of common and complex retinal conditions.
Course Highlights
- Advanced OCT & imaging training
- Diabetic Retinopathy workshops
- Retinal laser procedures
- Patient‑based seminars
- Case‑based learning approach

Interesting Retina Cases at TSA

Why Choose Medical Retina Training?
5‑Day Course Schedule
- Orientation to Medical Retina subspecialty
- Principles of fundus photography, OCT, FFA, and OCT-A
- Hands-on practice in performing and interpreting retinal imaging
- Case-based interpretation of normal and abnormal scans
- Clinical spectrum and staging of Diabetic Retinopathy and RVO
- Imaging-based diagnosis and treatment planning
- Hands-on experience with OCT/OCTA interpretation
- Practical demonstration of panretinal photocoagulation (PRP)
- Intravitreal injection technique – simulation and supervised training
- Clinical approach to AMD, CSR, and myopic CNVM
- Multimodal imaging in macular disorders (OCT, FA, OCTA)
- Hands-on interpretation of imaging in maculopathies
- Intravitreal anti-VEGF injection technique – practice on models/animals/patients
- Case discussions on treatment protocols and management of difficult cases
- Indications and applications of retinal lasers (focal, grid, PRP, barrage)
- Supervised hands-on retinal laser sessions
- Case discussions on complex and rare retinal presentations
- Participant-led case presentations and discussions
- Management of complications related to intravitreal injections and lasers
- Independent OCT interpretation exercises under faculty guidance
- Overview of new treatment modalities (gene therapy, long-acting delivery systems, biosimilars)
- Course summary, feedback, and certification
2‑Month Course Schedule
- 3Nethra Flora Fundus camera
- 3Nethra Flora Fundus fluorescein angiography
- Zeiss Cirrus HD OCT 5000
- Zeiss Cirrus OCT Angiography 5000
- Appa Argon Green laser, both slit lamp delivery &
- Laser indirect ophthalmoscopy
- Appasamy USG B-Scan
- Zeiss microscope
- Appa viewing system
- Stellaris PC (Bausch & Lomb, USA) vitrectomy system
- 23G & 25G vitrectomy sets with vitreo-retinal forceps & scissors
- Scleral buckling equipment with cryotherapy & endolaser
- Intra-vitreal Anti-Vegf injections: Avastin, Razumab, Accentrix, Eyelea, Pagenax, Vabysmo
- Intra-vitreal implants: Ozurdex
- Intra-vitreal antibiotics
- PST injection, Mydricaine injection
- Retinal lasers: Focal laser, PRP, sectoral laser, Barrage laser
- ROP Screening & treatment: ROP laser,Intravitreal injections, ROP surgery
- Surgical VR cases: Retinal detachment, Diabetic TRDs, Vitreous haemorrhage, Macular hole, ERM, Nucleus drop, SF-IOLs, Endophthalmitis
- The average number of patients attending the Retina OPD at TSA exceeds 600 per month. We serve a diverse range of patients, including Private cases, Ayushman cases, and International patients . Onaverage , weadminister approximately 150 intra-vitreal injections each month. Additionally, we perform around 250 retinal laser treatments and about 50 vitreoretinal surgeries monthly.
- Clinical training- Supervised participation in Retina OPD with exposure to diverse retinal pathologies including diabetic retinopathy, ARMD, Retinal vascular occlusions, Uveitis-related retinal disorders etc
- Diagnostic skills & interpretation: Interpretation of advanced retinal imaging modalities like OCT, OCT-A, FFA, B-scan.
- Engagement in structural seminars & case discussions.
- Observation & limited hands-on training in intravitreal injections & laser. A candidate can expect a minimum of approximately 10 lasers and about 3 intra-vitreal injections, with the possibility of more depending on the candidate’s calibre, by the end of the Training.
Vitreo-Retina Consultants




Medical Glaucoma Training Program
This short-term program is designed to provide ophthalmologists with practical exposure to the diagnosis and management of glaucoma. The course integrates clinical evaluation, imaging, perimetry, laser procedures, and surgical techniques with case-based discussions, enabling participants to strengthen both diagnostic and interventional skills in glaucoma care.
Course Highlights
- OCT for glaucoma: RNFL & GCC analysis
- Automated perimetry: interpretation and pitfalls
- Hands-on visual field testing and OCT scans
- Structure-function correlation
- Introduction to advanced imaging: OCT-A

Interesting Glaucoma Cases at TSA



Why Choose Medical Glaucoma Training?
5‑Day Course Schedule
- Orientation to Glaucoma subspecialty
- Optic disc evaluation – clinical pearls and disc photography
- Gonioscopy: principles, technique, and interpretation
- Hands-on practice with gonioscopy and optic disc documentation
- Case-based discussions on primary open-angle vs. angle-closure glaucoma
- Role of OCT in glaucoma: RNFL and GCC analysis
- Perimetry – standard automated perimetry, interpretation, and pitfalls
- Hands-on practice with visual field testing and OCT scans
- Case-based correlation of structural and functional damage
- Introduction to advanced imaging: OCT-A
- Current concepts in medical therapy of glaucoma
- Rational use of fixed drug combinations
- Indications, technique, and outcomes of laser iridotomy and laser iridoplasty
- Demonstration and hands-on practice with YAG laser PI
- Case-based discussions: medical vs. laser-first approach
- Indications and patient selection for surgery
- Trabeculectomy: steps, tips, and complications
- Glaucoma drainage devices – overview and selection criteria
- Wet lab / video-assisted training on trabeculectomy
- Case discussions on surgical decision-making
- Minimally Invasive Glaucoma Surgery (MIGS): current status and future scope
- Post-operative care and complication management
- Independent gonioscopy and OCT interpretation exercises
- Participant-led case presentations and clinical reasoning
- Course summary, feedback, and certification distribution
2‑Month Course Schedule
- 3Nethra Flora Fundus camera
- Zeiss Cirrus HD OCT 5000
- Zeiss Cirrus OCT Angiography 5000
- Appasamy Visual field analysis (Humphrey visual fields and Virtual perimetry
- Appasamy Nd: YAG peripheral Iridotomy
- Volk 3-mirror & 4-mirror gonioscope
- Zeiss 4-mirror gonioscope
- Appasamy Applanation tonometer
- Zeiss microscope
- Alcon Centurion Phaco machine
- Surgical gonio lens
- Harms trabeculotome
- Glaukos Ipism S
- Trabeculectomy with/without use of antimetabolites
- Combined Phacoemulsification and Trabeculectomy
- Congenital glaucoma surgeries: External trabeculotomy +- trabeculectomy
- MIGS procedures such as iStent and Kahook’s Dual Blade Goniotomy
- Combined Filtering surgeries with vitreoretinal surgeries
- Combined Filtering surgeries with corneal/ocular surface surgeries
- Aqueous drainage implants (valved or nonvalved),
- AC reformation, Needling of blebs, Revision of blebs and Management of overfiltering and leaking blebs (Autologous blood injections or patch grafts)
- Cyclodestructive procedures- Cyclocryotherapy, Trans scleral cyclophotocoagulation
Comprehensive evaluaon of Glaucoma paents& suspects
- Detailed history taking, slit lamp evaluation, applanation tonometry, indentation gonioscopy, optic disc and fundus evaluations.
- Functional tests like visual field analysis (Humphrey visual fields and Virtual perimetry)
- Structural tests – optic disc and retinal nerve fibre layer photography or imaging (OCT RNFL), OCT Angiography
- Anterior segment imaging - Anterior segment OCT In-depth knowledge and application of Medical and laser therapy in glaucoma
- Nd: YAG peripheral Iridotomy
- Argon Laser Suturolysis
- Postoperative bleb modulation
- Postoperative 5-Flurouracil injections, releasable sutures, bleb needling
Glaucoma Consultants


Refractive Surgery Training
This program focuses on comprehensive training in diagnostic evaluation, surgical planning, and advanced refractive surgical techniques (LASIK, SMILE, Femto-LASIK, PRK, ICL).
Course Highlights
- Topography & tomography
- Indications & patient selection
- LASIK/PRK/SMILE/ICL planning
- Complication management
- Wet lab & simulator exposure
- Advanced technology: excimer, femtosecond laser platforms, aberrometry

Refractive procedures done at TSA



Why Choose TSA for a Refractive Training?
5‑Day Course Schedule
- Orientation & course objectives
- Principles of refractive surgery & patient selection
- Hands-on training with Pentacam, Topography & Aberrometry
- Interpreting corneal thickness, curvature, biomechanics
- Case discussions: identifying suitable and unsuitable candidates
- Stepwise surgical planning for LASIK & PRK
- Hands-on wet-lab / simulator: microkeratome & femtosecond flap creation
- Nomogram adjustments & ablation profiles
- Video-based case discussions on complications & enhancements
- Principles of Small Incision Lenticule Extraction (SMILE)
- Indications, advantages, limitations
- Hands-on observation/assistance in live SMILE cases
- Training on docking techniques & lenticule dissection
- Management of intraoperative issues (suction loss, cap tears, lenticule remnants)
- Preoperative evaluation for ICL (Implantable Collamer Lens)
- Sizing, vault prediction, and patient counseling
- Hands-on ICL loading & insertion (wet lab/observation)
- Advanced ablation strategies (wavefront/topography-guided LASIK)
- Handling complex corneal profiles
- Management of complications: ectasia, flap issues, enhancement strategies
- Video-based case discussions & Q&A
- Post-op protocols, patient counseling, and certification
2‑Months Course Schedule
- Manual keratometer (Bausch & Lomb)
- Automated keratometer (Topcon-CT 800)
- Corneal topographer (Placido-based)
- Sirius (Scheimpflug + Placido tomography)
- Pentacam (Scheimpflug tomography)
- OCT anterior segment module (Zeiss Cirrus HD OCT 5000)
- IOLMaster 700 (biometry)- latest. One of the few centres in Delhi NCR to have
- OPD-Scan (aberrometry & corneal mapping)
- Specular microscope Pachymeter (ultrasound & optical)
- Tear film analysis devices (e.g., LipiView, Keratograph)
- Zeiss Visumax 500 (Smile & Femto LASIK)
- Excimer laser Mel 90
- LASIK
- C-LASIK
- FEMTO LASIK
- SMILE
- PRK
- ICL
- RLE/CLE
- Basics of refractive errors & corneal anatomy
- Principles of keratometry
- Corneal topography – Placido-based systems &
- Corneal tomography-Sirius scan – Scheimpflug & OCT-based
- Refractive surgery screening & patient selection
- PRK – Indications, technique, post-op protocol
- LASIK – Flap creation, excimer laser ablation
- SMILE – Surgical steps & advantages
- Complication management in refractive surgery
- ICL – Indications, sizing, vault assessment
- ICL surgical technique & post-op care1
- Dry eye & ocular surface disease in refractive surgery
- Post-operative care & enhancement strategies
- Patient counselling & documentation
- Case discussions & Training review
Refractive Consultants



Our Locations
Visit allied off‑site training centers.
The Sight Avenue
E-82-A, Ground Floor, Hansrai Gupta Rd, Greater Kailash I.
New Delhi, Delhi 110048
The Sight Avenue
Fortis Hospital, Escorts Okhla, New Delhi
The Sight Avenue
Fortis Hospital, Vasant Kunj, New Delhi
The Sight Avenue
243 P, Sector 38, Near Bakhtawar Chowk,
Gurgaon, Haryana 122001
The Sight Avenue
Manipal Hospital Gurgaon Address - Gol Chakkar, Carterpuri Rd, Block F, Palam Vihar, Gurugram, Haryana 122017
Ready to Advance Your Career?
Take the next step with comprehensive Training programs.
Call Us
+91 95604 65511
+91 95604 00982
Visit Website
www.thesightavenue.com
Visit Us
243 P, Sector 38, Near Bakhtawar Chowk, Gurgaon, Haryana 122001
